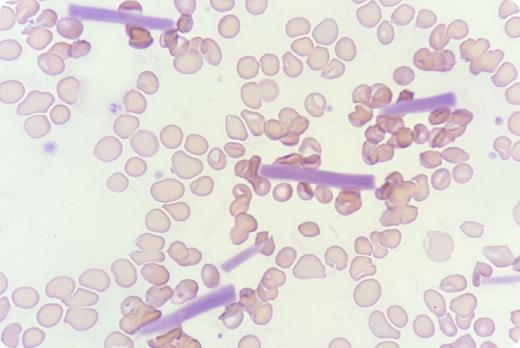
A 66-year-old Chinese woman with stage IV breast cancer presented to the clinic for assessment before her sixth cycle of palliative chemotherapy with cyclophosphamide and doxorubicin. Peripheral blood counts by automated blood count analyzer (DxH 800; Beckman Coulter) revealed that hemoglobin was 8.8 g/dL, leukocytes were 5.6 × 109/L, and platelets were 250 × 109/L, with a warning for platelet clumps, which prompted blood film review. Examination of blood film did not show platelet clumps but did show multiple extracellular cylindrical crystals that resolved with warming to 37°C. Serum testing confirmed the presence of cryoglobulin, and an immunofixation study showed a tiny immunoglobulin G κ band that could not be quantified due to low concentration. The patient had no lymphadenopathy, splenomegaly, features of vasculitis, or connective tissue disease but was on prophylactic lamivudine for chronic hepatitis B infection. Test results for anti–hepatitis C virus were negative. She declined further workup with bone marrow examination, and the cause of cryoglobulinemia could not be ascertained. / Cryoglobulins, in the form of amorphous pale staining material, are known to cause spurious platelet and leukocyte counts by automated blood count analyzers. Presentation as extracellular crystals is rarely reported in the literature.

A 66-year-old Chinese woman with stage IV breast cancer presented to the clinic for assessment before her sixth cycle of palliative chemotherapy with cyclophosphamide and doxorubicin. Peripheral blood counts by automated blood count analyzer (DxH 800; Beckman Coulter) revealed that hemoglobin was 8.8 g/dL, leukocytes were 5.6 × 109/L, and platelets were 250 × 109/L, with a warning for platelet clumps, which prompted blood film review. Examination of blood film did not show platelet clumps but did show multiple extracellular cylindrical crystals that resolved with warming to 37°C. Serum testing confirmed the presence of cryoglobulin, and an immunofixation study showed a tiny immunoglobulin G κ band that could not be quantified due to low concentration. The patient had no lymphadenopathy, splenomegaly, features of vasculitis, or connective tissue disease but was on prophylactic lamivudine for chronic hepatitis B infection. Test results for anti–hepatitis C virus were negative. She declined further workup with bone marrow examination, and the cause of cryoglobulinemia could not be ascertained.
Cryoglobulins, in the form of amorphous pale staining material, are known to cause spurious platelet and leukocyte counts by automated blood count analyzers. Presentation as extracellular crystals is rarely reported in the literature.
A 66-year-old Chinese woman with stage IV breast cancer presented to the clinic for assessment before her sixth cycle of palliative chemotherapy with cyclophosphamide and doxorubicin. Peripheral blood counts by automated blood count analyzer (DxH 800; Beckman Coulter) revealed that hemoglobin was 8.8 g/dL, leukocytes were 5.6 × 109/L, and platelets were 250 × 109/L, with a warning for platelet clumps, which prompted blood film review. Examination of blood film did not show platelet clumps but did show multiple extracellular cylindrical crystals that resolved with warming to 37°C. Serum testing confirmed the presence of cryoglobulin, and an immunofixation study showed a tiny immunoglobulin G κ band that could not be quantified due to low concentration. The patient had no lymphadenopathy, splenomegaly, features of vasculitis, or connective tissue disease but was on prophylactic lamivudine for chronic hepatitis B infection. Test results for anti–hepatitis C virus were negative. She declined further workup with bone marrow examination, and the cause of cryoglobulinemia could not be ascertained.
Cryoglobulins, in the form of amorphous pale staining material, are known to cause spurious platelet and leukocyte counts by automated blood count analyzers. Presentation as extracellular crystals is rarely reported in the literature.
For additional images, visit the ASH IMAGE BANK, a reference and teaching tool that is continually updated with new atlas and case study images. For more information visit http://imagebank.hematology.org.